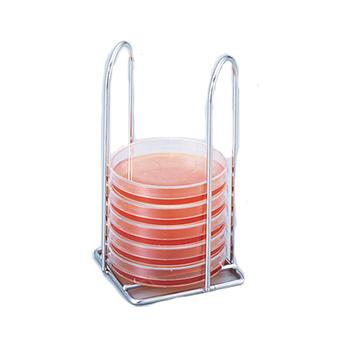

| 图片 |
名称 |
货号 |
折扣价 |
操作 |
 |
松浪(MATSUNAMI) 玻璃底培养皿 D11134H 1箱(100个),D11134H,2-2016-19 |
I1006722 |
2098.80 |
查看 |
 |
耐思(NEST) 多层细胞培养皿 771001 1个/包,8个/箱,771001,CC-9883-01 |
I1006723 |
4633.20 |
查看 |
 |
进口不锈钢培养皿,外径×高×厚度(mm)φ200×35×1.0mm |
I1006724 |
564.30 |
查看 |
 |
亚速旺白金接种环 φ0.5×50 (环IDφ5.0)(5根/袋) |
I1006725 |
2692.80 |
查看 |
 |
亚速旺(ASONE)VIOLAMO细胞培养瓶 VTC-F25V 1箱(10个/包x20包),2-8589-01 |
I1006726 |
1039.50 |
查看 |
 |
耐思(NEST) 多层细胞培养皿 771204 1个/包,4个/箱,771204,CC-9883-03 |
I1006727 |
5405.40 |
查看 |
|
进口培养皿架,92×92×165mm |
I1006728 |
178.20 |
查看 |
 |
亚速旺白金接种环 φ0.5×100(环IDφ5.0)(5根/袋) |
I1006729 |
3940.20 |
查看 |
 |
亚速旺(ASONE)VIOLAMO细胞培养瓶 VTC-F175V 1箱(5个/包x8包),2-8589-03 |
I1006730 |
752.40 |
查看 |
 |
亚速旺(ASONE)VIOLAMO细胞培养瓶 VTC-F25P 1箱(10个/包x20包),2-8589-04 |
I1006731 |
900.90 |
查看 |